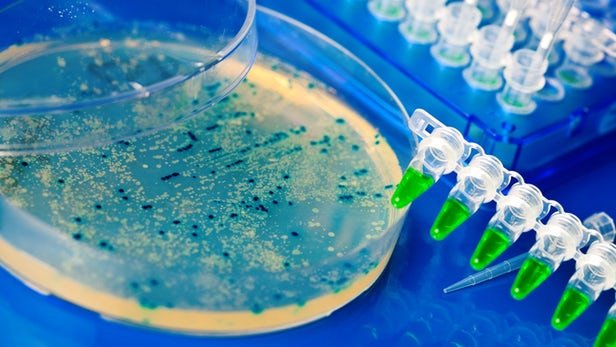

وب سایت خبری خبر جور در راستای ارائه اخبار در ضمینه های گونان اقدام به ارائه خبردرضمینه علمی دانشگاهی خود با بهترین گرداوری خبر از معتبر ترین منابع به نقل از خبرگذاری ایسنا نموده. لذا در این ضمینه شما را به مطالعه خبر فوق به نقل از خبر گذاری ایسنا مینماید.

مدیرگروه میکروبشناسی دانشگاه علوم پزشکی مشهد از بومیسازی تکنیک تشخیص بیماری شبه سل در این دانشگاه خبر داد.
به گزارش ایسنا، دکتر کیارش قزوینی با بیان اینکه باکتریها غالبا در محیط زندگی ما به فراوانی حضور دارند، اظهار کرد: این باکتریها در ایجاد عفونتهای مختلف نقش دارند و از طریق آب، مواد غذایی، هوا و دیگر عناصر محیطی میتوانند به بدن افراد وارد شوند و عفونت ایجاد کنند.
دانشیار باکتریشناسی دانشگاه علوم پزشکی مشهد با بیان اینکه تشخیص و افتراق مایکوباکتریومهای غیر سلی (NTM) به کمک تستهای بیوشیمیایی، اغلب زمانبر و پرزحمت بوده و تفسیر نتایج آن نیز چالشبرانگیز است، خاطر نشان کرد: به همین جهت، روشهای مولکولی مختلفی برای این منظور طراحی شده و مورد استفاده قرار گرفتهاند که از میان آنها روشی بر مبنای هیبریدیزاسیون معکوس یک ژن مشترک مایکروباکتریومی با پروبهای اختصاصی هر گونه، بر روی نواری از نیتروسلولز، موسوم به تکنیک LIPA از سایر روشهای معتبرتر است.
عضو مرکز تحقیقات مقاومتهای میکروبی دانشگاه علوم پزشکی مشهد با بیان اینکه کیت تجاری این تکنیک، اگر چه تأیید اداره غذا و داروی امریکا را دارد؛ اما بسیار گران است و برای هر بیمار ۱۰۰ دلار امریکا هزینه دارد، تصریح کردت: خوشبختانه در مرکز تحقیقات مقاومتهای میکروبی دانشگاه علوم پزشکی مشهد، برای اولین بار در کشور، اقدام به بومیسازی این تکنیک شد.
دکتر قزوینی اظهار کرد: اگر گونه باکتری که بیمار به آن آلوده شده، به دقت تشخیص داده نشود، ممکن است سیر درمان بیماری از مسیر صحیح فاصله بگیرد و علاوه بر اینکه داروهای زیادی مورد مصرف بیمار قرار بگیرد، تأثیر درمانی نیز در بیمار دیده نشود.
وی گفت: به همین جهت، تشخیص دقیق گونه باکتری، از اهمیت خاصی برخوردار است و از طرفی، اشتباه در تشخیص بیماری، ممکن است درمان نامناسب و در نهایت، شکست درمان را به دنبال داشته باشد.
مدیر گروه میکروبشناسی دانشگاه علوم پزشکی مشهد اظهار کرد: بیمارانی که به جهت یک بیماری زمینهای دچار ضعف سیستم ایمنی شدهاند، بیشتر در معرض این عفونتها قرار دارند و در صورت ابتلا، درمان بیماری زمینهای نیز تحت تأثیر قرار میگیرد و کار درمان بسیار دشوار خواهد شد.
دانشیار باکتریشناسی دانشگاه علوم پزشکی مشهد با بیان اینکه دانشگاه علوم پزشکی مشهد آمادگی پذیرش بیماران شناسایی شده اولیه را دارد، گفت: مناسبترین نمونه جهت ارسال به آزمایشگاه گروه میکروبشناسی دانشگاه علوم پزشکی مشهد واقع در مرکز درمانی قائم، باکتری مشکوک به NTM است و در صورت ارسال نمونه بالینی و یا ارجاع مستقیم بیمار است.
انتهای پیام
بزرگترین ارائه دهنده خبرهای گوناگون در ضمینه های مختلف در بستر وب به صورت فوق العاده سریع